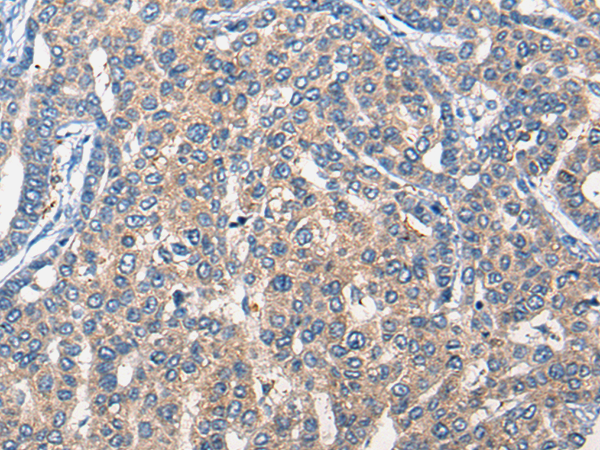

中文名稱(chēng): 兔抗MARK3多克隆抗體
英文名稱(chēng): Anti-MARK3 rabbit polyclonal antibody
別 名: microtubule affinity regulating kinase 3; KP78; CTAK1; PAR1A; Par-1a
相關(guān)類(lèi)別: 一抗
儲(chǔ) 存: 冷凍(-20℃)
宿 主: Rabbit
抗 原: MARK3
反應(yīng)種屬: Human, Mouse, Rat
標(biāo) 記 物: Unconjugate
克隆類(lèi)型: rabbit polyclonal
技術(shù)規(guī)格
|
Background: |
The protein encoded by this gene is activated by phosphorylation and in turn is involved in the phosphorylation of tau proteins MAP2 and MAP4. Several transcript variants encoding different isoforms have been found for this gene. |
|
Applications: |
ELISA, IHC |
|
Name of antibody: |
MARK3 |
|
Immunogen: |
Synthetic peptide of human MARK3 |
|
Full name: |
microtubule affinity regulating kinase 3 |
|
Synonyms: |
KP78; CTAK1; PAR1A; Par-1a |
|
SwissProt: |
P27448 |
|
ELISA Recommended dilution: |
5000-10000 |
|
IHC positive control: |
Human liver cancer |
|
IHC Recommend dilution: |
30-150 |

購(gòu)物車(chē)
幫助
021-54845833/15800441009
